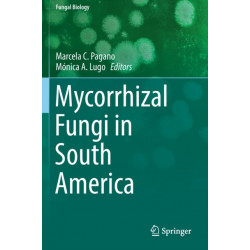
Mycorrhizal Fungi in South America

Ingen varer
Der er 3+ underkategorier
Latinamerika
-
Bemærk: Kan ikke leveres før jul.
The Oil of Brazil: Exploration, Technical Capacity, and Geosciences Teaching (1864-1968) (Bog, Paperback / softback, Engelsk)Levering: Skaffevare (forvent 14 - 30 hverdage) -
Bemærk: Kan ikke leveres før jul.
Mycorrhizal Fungi in South America (Bog, Paperback / softback, Engelsk)In these environments, different mycorrhizal associations (arbuscular / ericoid / orchidoid / ectomycorrhizal / mycoheterotrophic) are present in herbaceous plants, shrubs, and trees.
Levering: Skaffevare (forvent 14 - 30 hverdage) -
Bemærk: Kan ikke leveres før jul.
Mexican Banks and Foreign Finance: From Internationalization to Financial Crisis, 1973–1982 (Bog, Paperback / softback, Engelsk)Levering: Skaffevare (forvent 14 - 30 hverdage) -
Bemærk: Kan ikke leveres før jul.
The Mar Chiquita Salt Lake (Cordoba, Argentina): Ecology and Conservation of the Largest Salt Lake in South America (Bog, Paperback / softback, Engelsk)This book provides a comprehensive, updated syntheses of all the information available on... Læs mere
Levering: Skaffevare (forvent 14 - 30 hverdage) -
Bemærk: Kan ikke leveres før jul.
Resistance to Political Violence in Latin America: Documenting Atrocity (Bog, Paperback / softback, Engelsk)This book analyzes state terror documentation as a form of peaceful resistance to oppressive regimes through substantial research in human rights archives that registered violations perpetrated by Augusto Pinochet’s dictatorship in Chile.
Levering: Skaffevare (forvent 14 - 30 hverdage) -
Bemærk: Kan ikke leveres før jul.
Controversies in Latin American Bioethics (Bog, Paperback / softback, Engelsk)This book offers a first rate selection of academic articles on Latin American bioethics. Latin American bioethics has been, to an important extent, parochial and unable to meet stringent international standards of rational philosophical discussion.
Levering: Skaffevare (forvent 14 - 30 hverdage) -
Bemærk: Kan ikke leveres før jul.
Pharmacological Properties of Native Plants from Argentina (Bog, Paperback / softback, Engelsk)The aim of this book is to offer information about the Pharmacological Properties of Native Plants from Argentina to students, researchers and graduates interested in the fields of Ethnobotany, Pharmacognosy, Phytochemistry, Pharmacy, and Medicine.
Levering: Skaffevare (forvent 14 - 30 hverdage) -
Bemærk: Kan ikke leveres før jul.
Status and the Rise of Brazil: Global Ambitions, Humanitarian Engagement and International Challenges (Bog, Paperback / softback, Engelsk)This book explores the evolution of Brazilian foreign relations in the last fifteen years, with a focus on continuities and change. The volume tackles three sets of themes: diplomacy and diplomatic culture, international security and international development cooperation.
Levering: Skaffevare (forvent 14 - 30 hverdage) -
Bemærk: Kan ikke leveres før jul.
Mangroves and Aquaculture: A Five Decade Remote Sensing Analysis of Ecuador’s Estuarine Environments (Bog, Paperback / softback, Engelsk)This book uses five decades of map data, air photos, and medium to high-resolution satellite imagery to track the expansions of aquaculture and the loss of both estuarine and mangrove land covers in Ecuador.
Levering: Skaffevare (forvent 14 - 30 hverdage) -
Bemærk: Kan ikke leveres før jul.
Language Competition and Shift in New Australia, Paraguay (Bog, Paperback / softback, Engelsk)Providing fresh data on a previously under-researched community who are an extremely rare case of language shifting from English heritage... Læs mere
Levering: Skaffevare (forvent 14 - 30 hverdage) -
Bemærk: Kan ikke leveres før jul.
Social-ecological Systems of Latin America: Complexities and Challenges (Bog, Paperback / softback, Engelsk)However, in the case of Latin America, the complexity of social-ecological processes undermined a much-needed compilation of... Læs mere
Levering: Skaffevare (forvent 14 - 30 hverdage) -
Bemærk: Kan ikke leveres før jul.
The Politics of Public Accountability: Policy Design in Latin American Oil Exporting Countries (Bog, Paperback / softback, Engelsk)The authors present a causal mechanism linking ideas and policy outcomes through institutional arrangements,... Læs mere
Levering: Skaffevare (forvent 14 - 30 hverdage)

 for at udvide
kategorilisten.
for at udvide
kategorilisten.